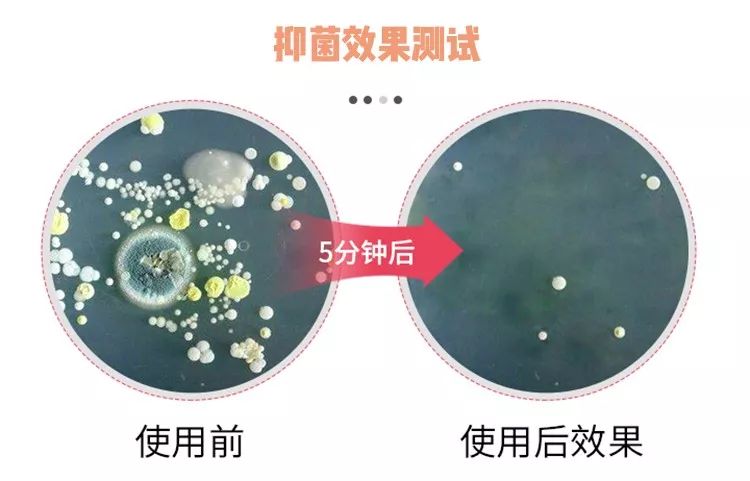
守护健康从消毒开始,守护用药安全从点滴做起

“23岁女子患上妇科病”,原因竟然是——不换*裤内**!

患病的芳芳说:“起初以为只是普通炎症,但症状一直加重就来医院检查了。”

芳芳解释说:“我就是有点懒,一条*裤内**能穿一年半载,清洗时也是堆了几天一起洗~
嗯?请问你对懒是有什么误解吗?

*裤内**这块小布里的白带分泌物、尿液污染、经血残留……滋生着成千上万的细菌。如果当天没有彻底清洗干净,细菌则会加倍滋生 。
想想一块小小的布里面有着密密麻麻的细菌在蛆动...巴不得赶紧把*裤内**丢了!

其实像她这样严重的妇科病就是这样活生生穿出来的!80%的妇科病都与*裤内**有关!

如果你平时对*裤内**卫生不注重,白带也异常多,那你可要注意了!
你内内上的金黄色葡萄球菌在发功了!
金黄色葡萄球菌

一天24小时跟我们亲密接触的内内,竟然是健康的凶手!
不跟*裤内**上的细菌拼个你死我活,都安心不下来。想要杀灭细菌,其实每天动动手就很easy了~

我相信有很多人是用洗衣液、洗衣粉或是肥皂来洗*裤内**的,但普通的碱性清洗剂,并不能有效杀灭细菌,手还越洗越像“钢丝球”。

所以选到一款能清洁彻底且能够消菌的清洁液就尤为重要了。
说到内衣清洗液,小编也有用过日本的和泰国的,但感觉效果和性价比都没有很好,还总担心买到假货。
打算尝试一下国货,找一款好用又舒心的内衣清洗液,我就向产品小姐姐求助了。她二话不说就给我推荐了这款——笙木之源茶树精油高浓度多效内衣清洗液

笙木之源这个品牌我种草挺久了,之前有用过他家和花王联合研发的沐浴露,确实hin好用。
这款清洗剂在湖南卫士的栏目里也被强烈推荐!

而且在网上随手一搜,大家对它都是打call不停,还称它是国货之光~

明星赵奕欢也在直播里推荐过这款清洗液,好用且性价比又高。

加上我对这个品牌的好感度还是蛮高的,所以就立马试用了。
第一次用就给了我很大的惊喜~内内上的血渍轻轻就洗干净了,而且晒干后摸着特别柔软,还有一股清新的白茶香~

香味闻着挺不错的,一查才发现,它跟迪奥、香奈儿、古驰、普拉达等等大牌都是来自奇华顿公司——世界上著名的香精香料公司。

迫不及待推荐给你们!
内内的保护伞
绝不放过每个细菌
内衣裤不像衣服裤子可以一股脑扔进洗衣机,手洗+用对清洗产品才能给私密部位一个健康环境~
推荐给你们之前我可是有做足功课的。笙木之源从效果、成分到味道和使用感都非常用心。

由于女性的生理结构比较特殊,*处私**容易藏匿细菌导致感染。我们穿了一整天的内内上会藏着成千上万的细菌。
用效果来说明

在加了清洗液的水里泡五分钟
有害细菌就没影儿了
对于危害性很高的金黄色葡萄球菌有高于99%的杀灭率,让人很安心~

有这么好的消菌效果都是因为在成分中添加了澳洲茶树精油 和 洋甘菊提取物,将细菌扼杀在摇篮里,为*处私**健康保驾护航。

茶树精油早在在二战期间就用于治疗伤口了。
而且选用的是澳洲茶树精油,看得出在成分上也很用心呢。

洋甘菊提取物有镇定舒缓的作用,有一点很加分的是它能够中和清洁液,接触的皮肤不会受到刺激。

市面上为了增加消菌力会添加刺激的化学物质,但笙木之源 只含植物成分 。
所以用它洗过的衣物摸上去不会粗糙、硬邦邦的,穿着更柔软舒适。

天然植物清洁力
让去污毫不费力
这款内衣清洗液的特别之处,在于专为解决顽固污渍而设的——蛋白酶。
有超强去渍力 的蛋白酶,进入到 纤维层深处 把污渍都给揪出来。

不管是大姨妈的血渍、*裤内**上的分泌物、哺乳期的奶渍,还是孕后恶露都能轻松搞定。

宝宝的衣服上的各种污渍,也难不倒它。

笙木之源全是利用天然植物本身的清洁力,没有添加 任何有害化学成分。只是运用先进的技术将清洁力提取出来而已。

守护*处私**健康,从一瓶内衣清洗液开始

它的清洁力真不是盖的,我找了一件用洗衣机洗过,准备淘汰的内衣来做对比。
洗衣机洗过的内衣会沾上很多小绒毛,一些细节部位也没洗干净。但用这个清洗液揉搓了一下,瞬间变白净了!

除了优秀的天然成分,研发团队还经过反复试验。
将清洗液的PH值调整到与人体皮肤相近的弱酸性,更有助于维持“妹妹”的弱酸环境。

而且比普通的碱性洗衣液要更温和不伤手,就算天天手洗也不会干燥粗糙~

不要以为只能洗内衣裤!它也同样可以用来清洗衣服裤 子和宝宝衣物。
几乎不用下手揉搓,用它泡上20~30分钟就自然干净了,完全解放双手!
加上泡沫也不多,直接过水就很干净了。

这款还是低泡浓缩型的,采用了美国路博润的液化提炼技术,用量会比普通清洁剂要省很多。
在污渍上挤上一丢丢,然后沾水搓洗就很轻松把污渍洗掉了。

一瓶多效 好用不止一点点
为什么说它一瓶多用?
它除了洗衣物之外可以是粉扑清洗剂、婴幼儿洗衣液 。

小编新买的化妆刷清洗剂还没到,就打算拿它来应付一下,没想到泡了一会就“唰”地洗干净了。

由于它不含苯、磷、荧光剂,加上温和亲肤的配方,孕妈用来清洗婴幼儿的衣物也是很OK的~

因为它是高浓缩型,用量不仅很省,而且还有500ml的大容量,用个大半年没压力,性价比超级高!
在这里要夸一下瓶口的设计 ,既卫生又好控制用量,不会像别的清洗液一倒就满手都是。

在最后还是要提醒大家:不要跟囤货似的堆内衣裤,而且!洗*裤内**真的要买专用的清洗液!

守护*处私**健康,就从这瓶内衣清洗液开始
给大家准备了超超划算福利:原价59/瓶,现在只要49/两瓶的白菜价!!!
被我安利的姐妹们已经抢先下单了,抓紧机会~